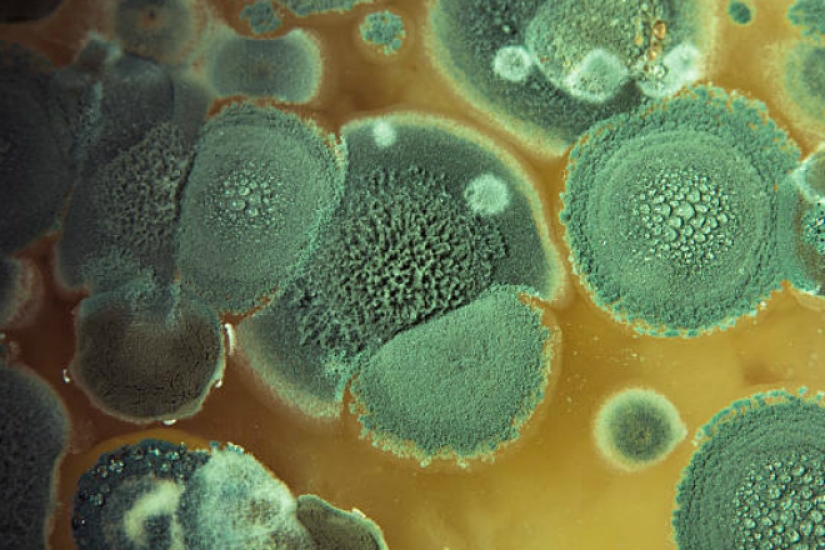

¿Qué sucede si usted come el pan con moho
Categorias: Comida y Bebidas | Mundo | Salud y Medicina
Por Pictolic https://mail.pictolic.com/es/article/que-sucede-si-usted-come-el-pan-con-moho.htmlEl moho puede crecer en el borde de un pedazo de pan y ni siquiera te darás cuenta. "Basta con pensar en lo que podría suceder?" — la mayoría dicen que será malo.

Algunos tipos de moho son inofensivos, pueden ser comido. Los ejemplos más notables — DorBlu queso brie o Camembert. Pero la placa en el pan son peligrosos para la salud. Puede causar alergias y problemas con el sistema respiratorio.
Una vez en el cuerpo, junto con el pan, el molde que va a perder el acceso al oxígeno, y por lo tanto la capacidad para reproducirse. Pero es tiempo de salir de las paredes del estómago el producto de la actividad, myotoxin.

Una pieza de pan con moho puede conducir a la acumulación de un gran número de myotoxin. En pequeñas cantidades se arregla con el hígado, pero las altas cargas conducir a la cirrosis. Todo comienza con una intoxicación grave, acompañada de diarrea y deshidratación.

Mayor acumulación de biotoxinas provoca la mutación de las células. No, no es que una mutación, lo que le permite ser Superman, y que conduce a la inflamación y la Oncología.
Lo peor es para las alergias. En el cuerpo de estas personas molde es casi seguro que la causa violenta reacción alérgica — angeloktisti de choque y angioedema. Sin un viaje al hospital ya no funcionan.
Pequeñas partículas de esporas de moho puede entrar en los pulmones a través de las vías respiratorias. Aquí está el más ambiente favorable para la reproducción y el resultado amenaza el desarrollo de asma.

El moho afecta a una porción mucho más grande de pan de lo que podemos ver. También recuerde que el tratamiento térmico no ayuda en la lucha contra el grano de moho. Conclusión: inspeccionar el pan con cuidado, si se notan las manchas de moho envolver todo el pan en la bolsa y deseche en la basura. Y si tienes la mala suerte de tener una pieza de molde, es mejor tomar un sorbente.
Palabras clave: La muerte | La salud y la medicina | La paz | El pan | El veneno | El moho | Los alimentos y bebidas
Publicar artículo de noticiasArtículos Recientes
Leonardo da Vinci fue acusado de ser aficionado a las orgías. Guillermo el Conquistador, a pesar de todos sus éxitos, fue llamado ...
¿Modestia? ¿Decencia? ¿Sentido del tacto? ¡No, no lo has oído! ¡Solo mira lo que están haciendo las personas de la siguiente ...
Artículos relacionados
Debido a los pequeños problemas, como una llamada perdida o una larga cola, el día está perdiendo la pintura, usted tiene que ...
Sí, Mascotas beneficio de nuestra salud y está comprobado por la ciencia. Su misma existencia, sin duda, nos hace más felices, ...
Ahora es posible de no mirar impotente alcohólicas mapa en busca de palabras conocidas, y de inmediato ordenó al camarero bebida ...

El fotógrafo documental estadounidense Bruce Davidson llegó al Reino Unido en 1960 por un par de meses para la revista Queen. La ...